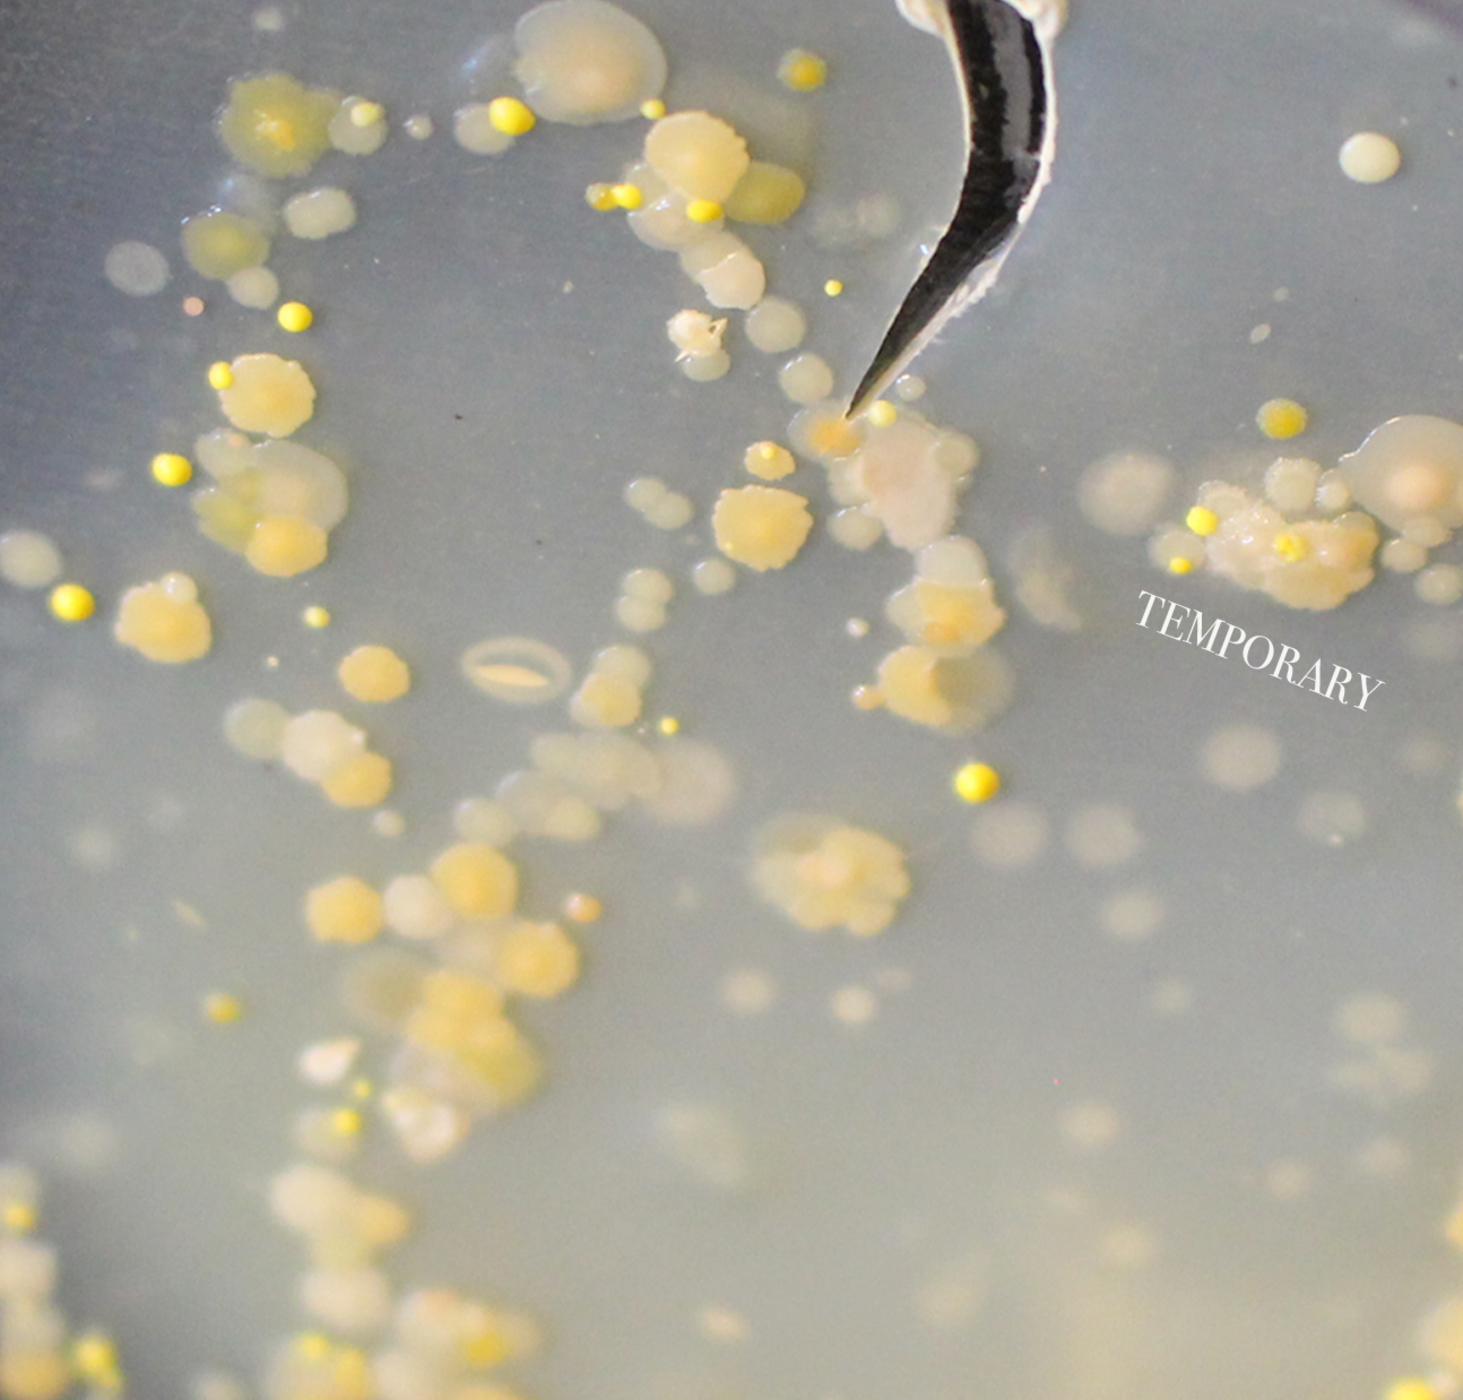

Temporary by Chunder Buffet
Tracklist
| 1. | Temporary | 2:57 |
Credits
released July 3, 2017
Recorded and Produced: Josh Rohs
Mastered: Matt McKeen
Label: Grey Records
Recorded and Produced: Josh Rohs
Mastered: Matt McKeen
Label: Grey Records